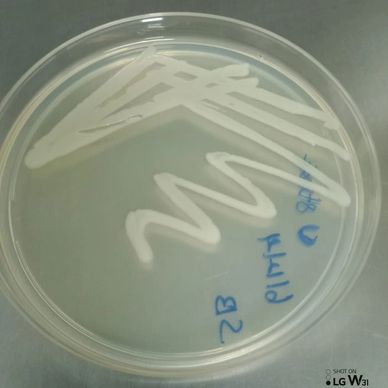
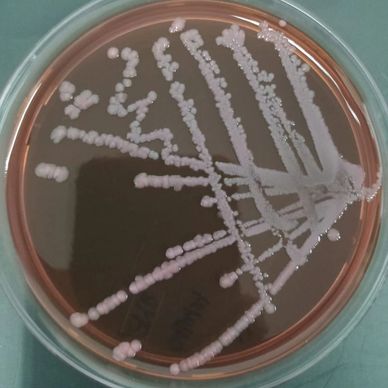
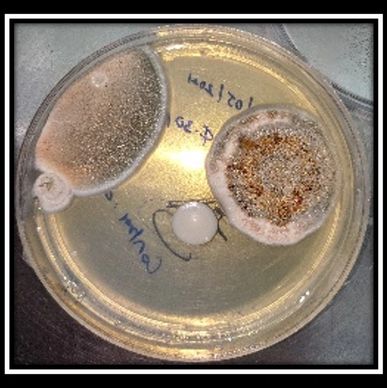

a new biotech products
FUNGAL PROMOTE MEDIUM

The Fungal promote medium which is supports to culture the fungal growth from the human specimen such as saliva, nasal (Sinus), oral & urine.
3PLY MASK

3PLY MASK
This website uses cookies.
We use cookies to analyze website traffic and optimize your website experience. By accepting our use of cookies, your data will be aggregated with all other user data.